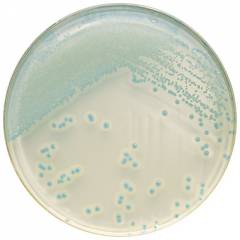

Мир животных окружает нас везде, как в деревнях, так и в самом большом городе. Они сожительствуют рядом с нами, некоторые из них являются нашей едой, а другие вредителями или даже просто членами семьи. Мало кто не любит животных, у многих они живут дома, особенно в сельской местности. Люди привыкают к питомцам и теряют свою бдительность в отношении тех опасностей, которые они могут нести. И это не только животная агрессия, которая может возникнуть в любой момент, а и те болезни, которыми они успешно делятся со своими хозяевами. К этим болезням относится и особо опасная инфекция – листерия.
Листериоз – это инфекционная патология, вызванная палочкой листерией, которая передается от животных (зоонозная инфекция), заболевание протекает с поражением, в первую очередь, иммунной и нервной систем, а также особо важных органов и, в тяжелых случаях, всего организма с развитием сепсиса.
Листериоз относится к редким заболеваниям, однако у людей с ослабленным иммунитетом, протекает крайне тяжело и часто приводит к смерти. В группе риска всегда оказываются грудные дети и беременные женщины.
- Немного статистики!
- Интересные факты!
- Возбудитель листериоза
- Характеристика возбудителя листериоза
- Способы инфицирования и патогенез листериоза
- Источник инфекции
- Пути инфицирования листериозом животных
- Пути инфицирования листериозом человека
- Группы риска по заболеванию листериозом
- Механизм развития (патогенез) листериоза
- Иммунитет при листериозе
- Клиническая картина листериоза
- Формы листериоза
- Симптомы листериоза в зависимости от формы
- Листериоз при беременности
- Клиническая картина врожденного листериоза
- Варианты течения листериоза
- Прогноз листериоза
- Диагностика листериоза
- Факты, указывающие на необходимость обследования больного на листериоз
- Методы лабораторной диагностики возбудителя листериоза
- Бактериологический и биологический методы
- Кожная проба на листериоз
- Полимеразная цепная реакция (ПЦР)
- Серологические методы диагностики
- Лечение листериоза
- Антибактериальная терапия листериоза
- Дезинтоксикационная и патогенетическая терапия при листериозе
- Профилактика листериоза
Немного статистики!
- Листериоз обычно проявляется спорадическими вспышками (единичные случаи), хотя описываются случаи массового распространения инфекции в ограниченном кругу людей, но это бывает довольно редко.
- По данным Всемирной Организации Здравоохранения, ежегодная заболеваемость листериозом в мире составляет от 2 до 3 случаев на 1 000 000 населения.
- Листерия одинаково распространена на всех континентах, во всех странах, независимо от климата и социального благополучия.
- Смертность наблюдается в 5-33% случаев заболевания листериозом.
Информация в статье носит справочный характер и не заменяет консультацию врача. Перед применением рекомендаций обратитесь к специалисту.
Интересные факты!
- Листериоз также называют болезнью реки Тигр, невреллезом, листериллезом, «силосной » болезнью.
- Название листерия получила в честь английского хирурга Джозефа Листера в 1940 году после ее открытия. Джозеф Листер (1827 – 1912 гг.) знаменит тем, что первым ввел в хирургическую практику антисептику и асептику. Также он открыл лактобактерии (молочнокислые бактерии) и доказал их пользу для человека.
- Листерий в окружающей среде очень много, а заболеваемость небольшая, что связано с тем, что не все заболевают листериозом и часто листериоз протекает бессимптомно у больных с сохранным иммунитетом.
- Чаще всего заболевают дети (особенно новорожденные), люди пожилого возраста (старше 50 лет), беременные.
- Листериоз во время беременности не так опасен для матери, как для плода и новорожденного ребенка, может привести к мертворождениям, выкидышам, замиранию беременности, а после рождения малыша – к менингитам, энцефалитам (поражение центральной нервной системы). У самой же будущей матери листериоз может протекать бессимптомно или малосимптомно, как обычная ОРВИ.
- Листериозом могут болеть абсолютно все виды животных и птиц, как дикие, так и домашние.
- Не выявлена зависимость вспышек заболевания от сезонности, так как возбудитель листериоза очень устойчив к различным цифрам на термометре.
- Заражению листериями также подвержены медицинские работники и ветеринары, контактирующие с больными.
- Тяжесть течения болезни прямо зависит от состояния защитных сил организма.
Возбудитель листериоза
Листериоз вызывает бактерия рода листерии.
Место листерии в иерархии живой природы
| Царство | Бактерии |
| Класс | Палочки (Бациллы) |
| Порядок | Бациллы (Bacillales) |
| Семейство | Листерии (Listeriaceae) |
| Род | Листерия (Listeria) |
| Патогенные виды |
|
Характеристика возбудителя листериоза
Способы инфицирования и патогенез листериоза
Источник инфекции
- Больные листериозом животные или птицы многих видов:
- Грызуны: крысы, мыши, кролики, зайцы, лисицы, норки и другие,
- Мелкий рогатый скот: овцы, козы и так далее,
- Крупный рогатый скот: коровы, быки и другие,
- Свиньи, дикие кабаны,
- Собаки, волки,
- Кошачьи,
- Птицы: куры, голуби, попугаи, гуси, утки, индюки и другие,
- Рыба: речная и морская рыба, креветки, раки и другие морепродукты,
- Обезьяны.
- Инфицированные листериозом люди.
Пути инфицирования листериозом животных
- Фекально-оральный путь заражения: животные употребляют зараженные корма (силос, сено, траву и так далее) и воду, в которых могут быть зараженные фекалии или останки трупов других животных, особенно грызунов.
- Алиментарный путь передачи листерий (для хищников): при поедании более мелких животных или их трупов.
- Контактный путь инфицирования: при непосредственном контакте с больными животными, через слюну, поврежденную шкуру и так далее.
- Воздушно-капельный путь: при инфицировании через органы дыхания во время кашля или чихания инфицированного животного.
- Половой путь передачи – передача происходит через сперму или влагалищные выделения, так как хронический листериоз может вызвать воспаление шейки, матки и придатков у женщин и простаты и мочеиспускательного канала у мужчин.
- Трансмиссивный механизм передачи инфекции (через кровь): листерии могут переносить многие сосущие насекомые (клещи, комары) от больного животного к здоровому.
- Трансплацентарный путь: от самки детенышу через плаценту или грудное молоко.
Пути инфицирования листериозом человека
- Алиментарный путь инфицирования (через продукты питания):
- Употребление мясных и рыбных продуктов, непрошедших термическую обработку (особенно колбасы, вяленные и копченые мясные продукты, полуфабрикаты, консервы, сырая и засоленная рыба).
- Через молочные продукты: молоко, сыры, кисломолочные продукты и так далее.
- Питье зараженной некипяченой воды, особенно из природных водоемов.
- Через овощи и фрукты, в которых могут быть продукты жизнедеятельности зараженных животных. Например, при хранении овощей и фруктов на складах, в подвалах, где живут мыши, крысы, оставляющие свои фекалии на продуктах.
Риск заразиться через продукты питания увеличивается при условии их длительного хранения в условиях холодильника и недостаточной термической обработки перед употреблением в пищу.
- Аэрогенный путь заражения: при отделке шкур, перьев, пуха, а также воздушно-капельным путем от больного человека (при громком разговоре, кашле, чихании).
- Контактный путь: через поврежденную кожу во время контакта с продуктами жизнедеятельности инфицированного животного, а также через слюну во время укуса. Контактный путь заражения может наблюдаться при контакте с больным листериозом человеком, например, акушеры могут инфицироваться при ведении родов у больной женщины через околоплодные воды и другие биологические жидкости.
- Трансплацентарное инфицирование плода и послеродовое заражение новорожденного ребенка: особо опасный путь инфицирования, так как риск заражения плода очень высокий и может привести к выкидышам, мертворождениям, задержке внутриутробного развития, а также к развитию врожденного листериоза у новорожденного малыша. Инфицирование листериями может произойти во время родов, воздушно-капельным путем от матери ребенку и через грудное молоко.
Группы риска по заболеванию листериозом
- Дети, особенно новорожденного, младенческого и дошкольного возраста (возраст от 0 до 6 лет),
- беременные женщины,
- пожилые люди и старики (старше 60 лет),
- люди, живущие с ВИЧ и другими иммунодефицитами,
- больные острыми и хроническими инфекционными заболеваниями, туберкулезом, сахарным диабетом, болезнями желудочно-кишечного тракта и так далее,
- пациенты, страдающие онкологическими или аутоиммунными заболеваниями, болезнями крови, а также другими болезнями, требующие длительного приема для лечения гормональных препаратов, антибиотиков и цитостатиков,
- профессиональные группы риска: ветеринары, животноводы, доярки, работники мясокомбинатов, фабрик по обработке шкур и кожи, охотники, рыбаки, акушеры и другие профессии, требующие контакта с инфицированными животными или людьми.
Механизм развития (патогенез) листериоза
Входные ворота инфекции (место внедрения листерий в организм человека):
- слизистая оболочка пищеварительной системы,
- миндалины,
- верхние дыхательные пути и легкие,
- слизистая оболочка глаз,
- поврежденная кожа,
- печень плода через плаценту и пуповину.
Листерии живут и размножаются только внутри клеток человека (внутриклеточный микроорганизм). В месте внедрения листерии начинают интенсивно размножаться. В ответ на чужеродного агента организм начинает выделять иммунные клетки, в первую очередь, фагоциты (клетки, которые поглощают в себя чужеродный белок и первыми начинают «переваривать» бактерии). «Верхом» на фагоцитах листерии попадают в лимфатические сосуды. Далее инфекция распространяется по организму.
Пути распространения листерий:
- Лимфогенный путь – распространение инфекции по лимфатической системе с последующим «поселением» (фиксацией) листерий в лимфатических узлах. Сначала поражаются регионарные лимфоузлы от ворот инфекции, затем листерии по ходу тока лимфы распространяются в другие группы. При этом лимфатические узлы увеличиваются в размере без классических признаков их нагноения. Здесь, в фагоцитах, происходит размножение листерий. Этот процесс сопровождается общей интоксикацией организма.
Также по лимфатической системе листерии могут попасть в печень и селезенку – органы, содержащие большое количество иммунных клеток, клинически это характеризуется выраженной интоксикацией и умеренным увеличением печени и селезенки (гепатоспленомегалия).
При достаточном иммунитете выделяются специфические антитела к листериям (иммуноглобулины), которые способны перебороть инфекцию.
- Гематогеннй путь – при недостаточном иммунном ответе инфекция из лимфатических узлов попадает в кровь, разрушая стенку кровеносных сосудов, развивается листериозный сепсис. При этом поражаются все внутренние органы и системы. Особенно опасны поражения в центральной нервной системе: развиваются менингиты, менинго-энцефалиты, абсцессы головного мозга. В пораженных органах формируются узелки некроза — листериомы.
Листериома – участок разрушенной ткани (ядерный детрит), содержащий в себе листерии и иммунные клетки (моноциты, лейкоциты, ретикулоциты).
При обширном поражении органов, несвоевременном лечении, может развиться полиорганная недостаточность (сердечная, дыхательная, печеночная, почечная недостаточности, парез кишечника), что влечет за собой смерть пациента. - Распространение через плацентарный барьер – при появлении листериом на плаценте беременной женщины, возможно попадание листерий в печень плода, а далее листерии кровотоком распространяются по всему организму малыша с развитием генерализованного листериоза.

Схематическое изображение механизма развития листериоза.
Иммунитет при листериозе
В результате перенесенного листериоза в организме развивается стойкий иммунитет, то есть человек повторно этим заболеванием уже не заболеет. Стойкий иммунитет связан с выделением в организме специальных клеток-памяти (Т-лимфоциты). Эти клетки вырабатываются после формирования специфических антител (иммуноглобулинов против листериоза).
На данный момент еще нет вакцины от листериоза, по поводу разработки специфической профилактики этой инфекции проводят множество исследований по всему миру. В основном уделяют внимание изобретению «убитой» вакцины, то есть введению в подопытных животных антигена листерии (листериолизин О), а не самой листерии. Использование живой вакцины (введение живых ослабленных микроорганизмов) показало неэффективность и высокий риск инфицирования и заболевания листериозом.
Клиническая картина листериоза
Инкубационный период (время от момента инфицирования до первых клинических проявлений инфекционного заболевания) при листериозе составляет от 3-х до 45-ти дней.
Листериоз не имеет каких-то специфических симптомов, отличающих его от других инфекционных заболеваний, и клиническая картина его часто напоминает обычную вирусную и бактериальную инфекцию. Даже тяжелое течение заболевания не дает каких-то особенных симптомов, позволяющих клинически дифференцировать листериоз от бактериального сепсиса или серозного менингита.
Формы листериоза
- Ангинозно-септическая форма (встречается чаще всего), развивается при алиментарном (через рот) или, реже, при воздушно-капельном пути инфицирования;
- Глазо-железистая форма – формируется при контактном механизме заражения, встречается достаточно редко.
- Нервная форма – может развиться при любом пути заражения, наиболее часто встречается у взрослых людей со сниженным иммунитетом.
- Тифоидная форма листериоза, также возникает в результате любого механизма инфицирования, чаще такой формой листериоза болеют дети с иммунодефицитами.
- Врожденный листериоз (гранулематозно-септическая форма) – инфицирование ребенка происходит от матери во время беременности или родов, а также в первый месяц жизни.
Симптомы листериоза в зависимости от формы
| Симптом или синдром | Как долго сохраняется? | При какой форме встречается? | Механизм развития симптома | Клинические проявления |
Интоксикационный синдром:
|
3-22 дней | Все формы листериоза | В момент попадания листерий в ворота инфекции, в лимфатические узлы или в другие органы, организм реагирует на антигены листерий и начинает сопротивляться, повышая температуру тела. Далее листерии начинают интенсивно размножаться. При этом в кровь выделяются эндотоксины и другие антигены. Продукты жизнедеятельности бактерий обладают токсическим и токсико-аллергическим действием на центральную нервную систему и весь организм в целом. | Лихорадка до 38-41оС, длительная, изнуряющая, сопровождается ознобом, сменяющимся чувством жара. При длительном повышении температуры могу покраснеть глаза и кожные покровы. Лихорадка сменяется снижением температуры тела ниже нормальных цифр, иногда это носит критический характер. Головная боль выраженная, постоянного или периодического характера. Отмечаются ноющие мышечные и суставные боли, боли в спине. |
| Диспепсические расстройства (нарушение пищеварения) | 5-30 дней | Все формы листериоза | При попадании листерий в желудочно-кишечный тракт, листерии поражают ее слизистую оболочку, мезентериальные (брыжеечные) лимфатические узлы, печень и селезенку. Листерии вызывают энтерит (воспаление тонкого кишечника), гепатит, мезоаденит (воспаление лимфоузлов брыжейки), что объясняет появление диспепсических расстройств. | Диспепсические расстройства при листериозе бывают не всегда, только при алиментарном пути заражения или при тифоидной форме.
|
| Увеличение лимфатических узлов | 5-30 дней | Все формы листериоза | В лимфатических узлах, в фагоцитах, происходит интенсивное размножение листерий. В ответ иммунная система пытается локализовать инфекцию, вырабатывая большое количество иммунных клеток, за счет этого и происходит увеличение лимфоузлов. | Сначала наблюдается увеличение лимфоузлов, расположенных в близости от ворот инфекции, затем, по ходу распространения инфекции может развиться полиадения (увеличение лимфоузлов более чем в пяти группах). При этом лимфоузлы могут быть размером от 5мм до 1-2 см, могут быть болезненными или безболезненными, без видимых признаков нагноения. |
| Увеличение печени и селезенки (гепато-спленомегалия) | 5-30 дней | Все формы листериоза (особенно нервная и тифоидная формы). | По лимфатической системе листерии могут попасть в печень и селезенку, продолжают в них размножаться. Из печени листерии могут попасть в кровеносное русло. | Этот симптом можно выявить при осмотре пациента, при пальпации живота наблюдаются увеличение печени и селезенки на 1-2 см, безболезненны или малоболезненны. |
| Ангина | 5-14 дней | Ангинозно-септическая форма | В миндалинах листерии размножаются, вызывая воспаление, а признаками воспалительного процесса всегда являются боль, покраснение, отек. | Виды листериозной ангины:
|
| Коньюктивит, отек век, сужение глазной щели. | 1-3 месяца | Глазо-железистая форма | Если слизистая оболочка глаза стала воротами инфекции, в ней развивается листериозное воспаление с последующим поражением лимфатических сосудов и регионарных узлов. Воспаление коньюктивы проявляется неприятными ощущениями, отеком, покраснением. |
Этот процесс может быть распространен на один или оба глаза. Глазо-железистая форма листериоза сопутствует увеличению околоушных и шейных групп лимфатических узлов. |
| Менингит |
3-45 дней | Нервная форма листериоза |
Поражение нервной системы происходит в результате гематогенного распространения инфекции (по кровеносному руслу). В нервных волокнах развиваются листриозные узелки (листериомы). При воспалении мозговых оболочек возникает менингит, при очаговом поражении головного мозга развивается менингоэнцефалит или энцефалит. Также возможно развитие абсцесса головного мозга – локальное поражение с некрозом тканей (появляется в результате слияния групп листериом). При поражении мозговых оболочек происходит отек головного мозга с повышением спинномозгового давления, что и определяет течение менингита и менингоэнцефалита. «Лишняя» жидкость раздражает нервные центры и рецепторы. Поражение головного мозга может привести к его отеку, на фоне нарастания которого пациент может умереть. | Симптомы менингита:
При осмотре пациента врач может выявить менингиальные симптомы:
|
| Менингоэнцефалит, энцефалит, абсцесс головного мозга | 3-45 дней | Поражение головного мозга может быть изолированным – энцефалит, или протекать с менингитом – менингоэнцефалит. При энцефалите появляется очаговая симптоматика поражения головного мозга:
|
||
| Сепсис | Индивидуально* | Тифоидная форма | При попадании листерий в кровь развивается бактериемия, инфекция распространяется по всему организму, что приводит к недостаточности жизненно важных органов. Этот процесс сопровождается массивным иммунным ответом и токсико-аллергической реакцией. Токсины влияют на красный костный мозг, печень, селезенку, что приводит к нарушению свертываемости крови. Бактериемия может привести к развитию инфекционно-токсического шока, возможный исход которого – полиорганная недостаточность и смерть. Также причиной смерти может стать септический эндокардит (поражение сердца). |
Основные признаки сепсиса:
|
*Начало сепсиса и длительность заболевания зависит от способа распространения инфекции и тяжести заболевания.
Листериоз при беременности
Опасность листериоза при беременности заключается в том, что заболевание чаще имеет легкое бессимптомное или малосимптомное течение, не нарушает общего состояния женщины и не диагностируется, соответственно, и не лечится.
Самые частые жалобы при листериозе у беременных:
- повышение температуры тела до 38-39оС,
- головная боль,
- мышечные и суставные боли,
- боль, першение, сухость в горле,
- возможен коньюктивит,
- насморк, кашель,
- изменения стула (чаще диарея).
Как мы видим – это все симптомы ОРВИ (острой респираторной вирусной инфекции).
Распространенные формы листериоза (нервная и тифоидная) у беременных встречается редко. Листериоз может возникнуть на любом сроке беременности, чаще в III триместре.
А вот на плод листериоз действует пагубно.
В зависимости от срока беременности развиваются следующие осложнения со стороны плода:
- выкидыш в I-II триместрах беременности,
- задержка внутриутробного развития, развитие грубых аномалий развития – во II-III триместрах,
- мертворождение – в III триместре,
- врожденный листериоз, преждевременные роды (недоношенные дети) – в III триместре.
Клиническая картина врожденного листериоза
Врожденный листериоз – наиболее тяжелое проявление инфекции, имеет очень высокий риск смертельного исхода.
Листерии попадают в пупочную вену и печень плода через пораженную плаценту, быстро распространяются по всему организму плода, вызывая сепсис. При выделении мочи и мекония в околоплодные воды, ребенок инфицируется повторно, что не дает хороших прогнозов в отношении жизни и здоровья плода.
По всем органам и на слизистых оболочках у малыша формируются гранулемы (листериомы), патологоанатомическая и клиническая картина очень напоминает милиарный туберкулез. В литературе ранее это состояние называли псевдотуберкулезом, путая врожденный листериоз с иерсиниозом (возбудитель псевдотуберкулеза).
Все симптомы раннего врожденного листериоза обычно развиваются в первые часы жизни.
Основные симптомы врожденного листериоза:
- Недоношенность – роды на сроке 28-37 недель.
- Задержка внутриутробного развития – малый вес и рост.
- Лихорадка – ребенок рождается с температурой тела от 37 до 39-40оС.
- Нарушение дыхания:
- одышка,
- шумное дыхание (стридор),
- приступы остановки дыхания (апноэ), которые тяжело купируются и могут привести к смерти ребенка,
- участие в акте дыхания вспомогательных мышц (раздувание крыльев носа, втяжение межреберных промежутков, живота).
- Нарушение кровообращения:
- цианоз (синюшность) конечностей, носогубного треугольника,
- тахикардия (учащение сердцебиения),
- шумы в сердце.
- Изменения на рентгенограмме органов грудной полости: мелкие (просовидные) очаговые тени по всей легочной ткани, рентген-картина напоминает милиарный туберкулез.
- Высыпания по телу: сыпь полиморфная (разнообразная), элементы сыпи представлены папулами, пятнами (синячками или петехиями), сыпью покрыта практически вся поверхность кожи.
- Возможны симптомы менингита и менингоэнцефалита:
- судороги (клонико-тонические), ребенка выкручивает в дугу,
- повышение мышечного тонуса,
- появление менингеальных знаков и патологических рефлексов,
- изменения в спинномозговой жидкости, характерные для гнойного менингита,
- нарастание отека головного мозга.
- Увеличение печени и селезенки.
Помимо раннего врожденного листериоза бывает поздний листериоз новорожденных, инфицирование при этом происходит во время родов или непосредственно сразу после родов. При этой форме ребенок рождается здоровым и доношенным, а симптомы заболевания проявляются через несколько дней или недель.
Варианты течения листериоза
- Острое течение – быстрое развитие симптомов с развитием яркой клинической картины, чаще встречается у новорожденных детей и детей до 1 года, а также у ВИЧ-позитивных лиц.
- Подострое течение – самый частый вариант течения листериоза, характеризируется постепенным развитием симптомов.
- Хроническое течение – характеризуется стертой клинической картиной, постепенным началом, длительным периодом с рецидивами.
- Абортивное течение – острое начало и быстрое выздоровление, даже без проведения антибактериальной терапии.
- Бактерионосительство – бессимптомное течение, но выделяют листерии в окружающую среду.
- Рецидивирующее течение – при листериозе встречается часто, особенно в случаях когда не был пройден курс антибиотиков, рецидив может проявиться в виде распространенной формы листериоза (нервной и тифоидной) с тяжелым течением.
Прогноз листериоза
- Выздоровление с формированием пожизненного иммунитета (при сохранном иммунитете – в 70%, при иммунодефиците – в 40% случаев);
- Летальный исход (в зависимости от состояния иммунной системы 30 и 60% соответственно), врожденный листериоз в большинстве случаев приводит к смерти ребенка в первые дни или недели жизни.
- Остаточные изменения перенесенного листериоза в виде парезов, параличей, умственной недостаточности, судорожного синдрома и гидроцефалии у детей, а также других осложнений поражения нервной системы, хронический пиелонефрит, гепатит и тому подобное.
Диагностика листериоза
Учитывая, что специфических только для листериоза симптомов нет, диагноз листериоза выставляется на основании выявления возбудителя лабораторными методами диагностики.
Факты, указывающие на необходимость обследования больного на листериоз
- Анамнез (история) жизни:
- профессиональная деятельность, связанная с животными и продуктами питания,
- проживание в сельской местности с ведением животноводства,
- употребление пищи со складов или подвалов, где есть следы проживания грызунов,
- употребление некипяченого молока,
- питье неочищенной воды из водоемов,
- выкидыши и мертворождения в анамнезе беременной женщины,
- укусы животных,
- наличие в окружении больных листериозом.
- Анамнез болезни:
- повторные ангины с лихорадкой у беременных,
- листериоз в анамнезе,
- проявление симптомов заболевания в первые часы жизни у новорожденных,
- наличие симптомов листериоза на фоне СПИДа, иммунодефицитов, сахарного диабета, рака и других заболеваний, снижающих иммунитет,
- развитие менингита на фоне ангины,
- длительная лихорадка,
- длительное течение заболевания и так далее.
- Симптомы и жалобы:
- начало болезни напоминает грипп,
- длительная лихорадка,
- ангина,
- увеличенные лимфоузлы в нескольких группах (не только региональные),
- коньюктивит,
- полиморфная сыпь по всему телу,
- увеличение печени и селезенки,
- диспепсические расстройства,
- менингит, менигоэнцефалит,
- развитие сепсиса.
- Объективный осмотр:
Критерии осмотра Ангинозно-септическая и глазо-железистая формы Нервная и тифоидная формы Общее состояние Удовлетворительное или средней степени тяжести. Тяжелое или крайне тяжелое. Сознание Сохранено. Сохранено, спутанное или нарушение сознания, вплоть до комы. Температура тела Повышено до 38-39оС в течение 5-10 дней, а потом происходит резкое снижение температуры тела менее 36оС. Повышено до 38-39оС длительно до 1 месяца. Кожные покровы и видимые слизистые Обычные или бледные, редко желтушные. Сыпь при нераспространенных формах может отсутствовать.
Зев гиперемирован, миндалины увеличены, возможны гнойные «точки» или пленки. Можно выявить узелковые высыпания на зеве и миндальных дужек.
При глазо-железистой форме наблюдается покраснение глаз, гнойные выделения в уголках, сужение глазной щели, отек век.Бледные, возможно с желтушностью, наблюдается цианоз (синюшность) вокруг глаз или носогубного треугольника, пальцев конечностей. Можно выявить периферические отеки. На коже высыпания.
Характеристика сыпи:- полиморфная – различная по размеру, характеру и цвету,
- местами сливается,
- элементы сыпи: папулы, пятна, узелки, петехии и геморрагии (синяки),
- высыпания расположены на фоне неизмененной кожи.
Изменения горла и глаз в большинстве случаев отсутствуют.
Лимфатические узлы Лимфатические узлы увеличены в нескольких группах, не только околоушные и подчелюстные, но и шейные, подмышечные и паховые. Лимфоузлы безболезненные или малоболезненные при пальпации, плотные или плотно-эластические по консистенции, без видимых признаков нагноения (флуктуации), их размер может быть от 0,5 до 2 см. Лимфатические узлы при распространенных формах листериоза чаще всего не изменены. Сердечно-сосудистая система При язвенно-пленчатой форме возможна тахикардия – учащение сердечных сокращений более чем 90 раз в минуту. Артериальное давление в норме. - тахикардия,
- нарушение периферического кровообращения (цианоз),
- снижение артериального давления ниже 90/60 мм рт. ст.,
- возможно появление шумов в сердце, связанных с перикардитом или эндокардитом.
Дыхательная система При наличии кашля можно выслушать жесткое дыхание, рассеянные сухие хрипы. Одышка не типична. При тифоидной форме – одышка, крепитирующие хрипы над легкими.
При тяжелом состоянии может быть нарушен акт дыхания, при этом дыхание возможно только через аппарат искусственной вентиляции легких.Нервная система Без патологических изменений. - Положительные менингеальные знаки, судороги, повышение тонуса мышц, парезы и параличи при менингитах.
- Птоз, анизокория, появление патологических рефлексов, нарушение акта глотания, «симптом заходящего солнца» — нарушение движения глазных орбит при энцефалитах.
Органы желудочно-кишечного тракта Живот мягкий, безболезненный, перистальтика сохранена, возможно незначительное увеличение печени и селезенки. Живот несколько вздут, может быть болезненным при пальпации. Печень и селезенка увеличены. Возможно развитие пареза кишечника – отсутствие перистальтики. Мочеиспускательная система Обычно без патологических изменений. Часто выявляют симптомы пиелонефрита – положительный симптом Пастернацкого – боли при поколачивании в области поясницы по бокам от позвоночного столба. При тяжелом течении возможно уменьшение выделяемой мочи или ее полная задержка. - Общий анализ крови:
- анемия – снижение уровня гемоглобина менее 120 г/л,
- лейкоцитоз – увеличение количества лейкоцитов более 9 Г/л,
- увеличение количества моноцитов – более 10%,
- ускорение СОЭ более 10-15 мм/ч,
- снижение уровня тромбоцитов – менее 180 Г/л (при тифоидной форме листериоза).
- Общий анализ мочи:
- Может быть без патологических изменений,
- При поражении почек (тифоидная форма) — повышение уровня лейкоцитов мочи более 5 в поле зрения, появление белка, слизи, реже эритроцитов.
- Анализ спинномозговой жидкости (проводят при нервной и тифоидной формах):
- повышенное давление спинномозговой жидкости (ликвора) при люмбальной (спинномозговой) пункции,
- ликвор мутный,
- лейкоцитоз (более 6 клеток), в начале болезни уровень лейкоцитов 100-500 кл за счет лимфоцитов и нейтрофилов, а в разгар менингита уровень лейкоцитов 500-1500 кл за счет нейтрофилов,
- повышение уровня белка выше 0,35 г/л,
- глюкоза и хлориды в ликворе не повышены,
- иногда можно выявить листерии, а вернее, Грам-положительные палочки.
Спинномозговой пункции бояться не надо. Правильно проведенная пункция не несет каких-либо опасностей. Кроме диагностического значения, эта процедура способна облегчить состояние больного менингитом, за счет уменьшения количества ликвора (при менингитах ликвор вырабатывается в большем количестве, что и определяет тяжесть состояния больного).
Методы лабораторной диагностики возбудителя листериоза
Бактериологический и биологический методы
Бактериологический метод заключается в посеве материала на питательные среды. Сначала материал сеют на твердые питательные среды, затем, при необходимости, пересевают на среды, содержащие кровь.
Материалы для посева с целью диагностики листериоза:
- слизь из зева,
- кровь,
- спинномозговая жидкость,
- выделения из глаза,
- кал,
- моча,
- пуповинная кровь,
- биоптаты (материал, полученный при пункции) лимфатических узлов,
- меконий новорожденных,
- патологоанатомические материалы (из головного мозга, печени, селезенки и других органов) и так далее.
Эффективно обследование на листериоз бактериологическим методом в течение первых 7-10 дней от развития первых симптомов заболевания.
Положительный результат посева на листериоз – получение специфических гладких колоний прозрачно-голубого или зеленого цвета, нитевидной формы, небольших размеров.

Полученные культуры исследуют дополнительными микробиологическими методами:
- Метод микроскопии – выявление палочек под микроскопом, обычно перед этим проводят окраску препарата по методу Грама.
- Тест чувствительности к антибиотикам – определение наличия устойчивости к антибактериальным препаратам, необходим для определения эффективной тактики антибактериальной терапии.
- Биологический метод – метод исследования бактерий путем заражения лабораторных животных. На данный момент этот метод используют лишь в сомнительных случаях, когда бактериологический и микроскопический методы не дали достоверного результата, ранее этот метод использовался более широко. Для исследования на листериоз лучше всего подходят белые мыши или морские свинки, их заражают суточной культурой (выращенной на бульоне) путем закапывания в глаза (у животных через 2-3 дня развивается гнойный коньюктивит) или вводят в кровь. Животные необходимы для размножения листерий. При развитии листериоза мыши погибают в течение 3-6 дней. Наблюдают за клиническими проявлениями заболевания у животных, а после смерти исследуют гистологический материал на листериоз методом посева, микроскопии и гистологии.
Преимущества и недостатки бактериологического и биологического методов:
- достоверность результатов самая точная,
- недостаток – длительность проведения исследований: так предварительный результат получают только через 2 недели, а окончательный – через 1 месяц.
Кожная проба на листериоз
Кожную пробу необходимо проводить на 6-10-й день от начала клинических проявлений заболевания. При этом внутрикожно вводят листериозный антиген. Положительная проба – это образование покраснения и инфильтрата диаметром более 10 мм в месте введения препарата. Эта проба малоспецифична и не может быть основным критерием для постановки диагноза.
Полимеразная цепная реакция (ПЦР)
ПЦР – это молекулярно-генетический метод диагностики, выявляющий генетический материал листерий.
Положительный результат – обнаружение ДНК листерий.
Преимущества ПЦР:
- достоверность результата более 98%,
- быстрый результат – в течение нескольких часов, поэтому ПЦР можно использовать как экспресс-тест,
- специфичность – выявляют сам возбудитель, а не результаты его жизнедеятельности,
- высокая чувствительность – выявление даже небольшой концентрации бактерий в материале,
- возможность исследования на любом этапе заболевания, не выдерживая определенные сроки, как при серологических и бактериологических методах, также возможна диагностика на фоне антибактериальной терапии, что обычно уменьшает достоверность других методов диагностики листериоза,
- возможность исследования любого биологического материала: крови, кала, спинномозговой жидкости и так далее.
Недостаток метода: высокая стоимость исследования.
Серологические методы диагностики
Серологические методы – методы, направленные на выявление специфических антител к листериям. Их назначение целесообразно со второй недели заболевания. Наличие антител против листерий сохраняются в течение нескольких лет после заболевания.
Виды серологических реакций:
- ИФА (иммуноферментный анализ),
- РА (реакция агглютинации),
- РСК (реакция связывания комплемента),
- РНГА (реакция непрямой гемагглютинации).
Материал для исследования:
- кровь,
- спинномозговая жидкость.
Положительный результат: наличие антител в титре от 1:250 до 1:5000.
Недостатки метода:
- малая достоверность результатов, на основании их можно только заподозрить листериоз;
- низкая специфичность исследования (листерийные антигены по своей структуре очень схожи с другими инфекционными возбудителями, поэтому часто получают ложноположительные или ложноотрицательные результаты), а сам метод не выявляет возбудителя, а обнаруживают антитела;
- при выраженном иммунодефиците (например, при СПИДе) организм утрачивает возможность образования антител, ИФА при этом будет отрицательным даже при самом тяжелом течении листериоза;
- возможность проведения анализа только на поздних сроках болезни (начиная со второй недели от первых симптомов).
Преимущества метода:
- быстрый результат – экспресс-метод,
- возможность исследования любого биологического материала,
- доступность.
При выявлении листериоза у человека, имеющего домашних питомцев, необходимо обследовать всех животных на листериоз, при обнаружении заболевания, их надо пролечить, мясо животных необходимо тщательно термически обработать, молоко таких животных не пригодно к использованию. Обязательно в неблагополучных по листериозу животноводческих хозяйствах провести дезинфекцию и дератизацию (уничтожение грызунов).
Лечение листериоза
Лечение листериоза требует комплексного подхода, должно быть направлено на микроорганизм (антибактериальная терапия) и на макроорганизм (дезинтоксикационная, противовоспалительная, патогенетическая терапии).
Факторы, от которых зависит успех лечения листериоза:
- своевременность диагностики листериоза,
- состояние иммунитета, возраст пациента,
- форма листериоза – при ангинозно-септической и глазо-железистой формах прогноз излечения благоприятный,
- своевременность начала лечения (не позднее 5-7 дня заболевания),
- адекватная, непрерывная антибиотикотерапия,
- комплексный подход.
Лечение листериоза проходит только в условиях стационара инфекционной больницы или отделения. При развитии нервной формы и сепсиса больной переводится в реанимационное отделение инфекционного учреждения.
Антибактериальная терапия листериоза
| Группа препаратов | Препарат | Как применяется? | Особенности применения |
| Препараты пенициллинового ряда | Ампициллин | Взрослые: внутрь 250-500 мг 4 раза в сутки, для внутримышечного введения – 250-500 мг 4 раза. Дети: внутрь 12-25 мг/кг/сут за 4 приема, внутримышечно – 25-50 мг/кг/сут за 4 приема. |
Антибиотики пенициллинового ряда для лечения листериоза назначают в комплексе с аминогликозидами. Используют для лечения беременных. |
| Аугментин (амоксициллин/ клавулоновая кислота) |
Взрослые: таблетки 250/125 или 500/125 мг по 1 таб. 3 раза в сутки, 875/125 мг 2 раза в сутки; раствор для инъекций – 1000/250 мг внутривенно капельно 3-6 раз в сутки (зависимо от тяжести течения). Дети: суспензия – 40/10 мг/кг/сут. за 3 приема; раствор для инъекций – 25/5 или 50/5 мг/кг/сут 2-4 раза в сутки (зависимо от тяжести состояния). |
||
| Тетрациклиновый ряд | Тетрациклин | 0,25 – 0,4 г каждые 6 часов. Препарат применяют только для лечения взрослых. | Тетрациклин часто вызывает побочные действия, наиболее частые из них – аллергические реакции и лекарственный гепатит. Противопоказан при беременности. |
| Макролиды | Эритромицин | Взрослые: 0,25 г 4 раза в сутки, Дети: 30-50 мг/сут за 4 приема. |
|
| Аминогликозиды | Гентамицин | Взрослые: 3-5 мг/сут за 2-4 приема. Дети: 2-5 мг/кг в 3 приема. Препарат вводят внутримышечно или внутривенно капельно. |
Аминогликозиды не эффективны при нервной форме листериоза, так как не проникают через гематоэнцефалический барьер. Эффективны схемы с препаратами пенициллинового ряда. Часто вызывают побочные действия, особенно в отношении слухового нерва (может привести к тугоухости — глухоте) – ототоксический эффект. |
| Тобрамицин | Взрослые: 2-3 мг/кг/сут за 3 приема, дети: 2-5 мг/кг/сут за 3приема. Препарат вводят внутримышечно или внутривенно капельно. Тобрамицин в виде глазных капель эффективен при глазо-железистой форме листериоза. | ||
| Сульфаниламиды | Ко-тримоксазол (сульфаметоксазол в комбинации с триметопримом) | Взрослые: 960 мг 2 раза в сутки внутрь, для внутримышечного введения – по 3 мл 2 раза в сутки, внутривенного капельного – 10-20 мл, разведенного в 200 мл физ. раствора . Дети: до 6 мес. – 120 мг, 6 мес. – 5 лет – 240 мг, 6-12 лет – 480 мг внутрь 2 раза в сутки. |
Препарат эффективный при тяжелом течении заболевания, а также при врожденном листериозе. Возможен длительный прием – 1-3 месяца. |
Антибиотикотерапия назначается непрерывным длительным курсом (в среднем 14-21 дней) до прекращения лихорадки и еще 5-7 дней безлихорадочного периода.
Цефалоспорины (цефтриаксон, цефтазидим и другие) на листерии не действуют.
Если получена культура листерий при бактериологическом методе диагностики, проводят тест чувствительности к антибиотикам. Идеально назначать антибактериальную терапию согласно результатам данного теста.
Дезинтоксикационная и патогенетическая терапия при листериозе
Учитывая наличие бактериемии, выраженной интоксикации при листериозе, больному необходимо справиться с листерийными антигенами, вывести продукты жизнедеятельности листерий из организма. Дезинтоксикацию необходимо проводить на фоне начала антибиотикотерапии, так как антибиотики способствуют быстрой массовой гибели бактерий, при этом в кровь выделяется большое количество эндотоксинов. В этот момент может развиться инфекционно-токсический шок (ИТШ), а дезинтоксикация уменьшает риск его возникновения.
Патогенетическая терапия направлена на восстановление нарушенных функций организма.
Методы дезинтоксикационной и патогенетической терапии при листериозе.
| Метод | Показания к проведению и механизм действия | Как проводится? |
| Дезинтоксикационная терапия | Дезинтоксикация способствуют выведению продуктов жизнедеятельности бактерий. Она основана на введении в кровеносное русло инфузионных растворов методом форсированного диуреза (назначения мочегонных средств, для ускорения выведения введенной жидкости с вредными веществами, токсинами почками). Дезинтоксикационная терапия показана при тифоидной и ангинозно-септической формах листериоза, при нервной форме инфузионная терапия проводится с осторожностью. |
Этапы введения нфузионных растворов для форсированного диуреза:
Объем вливаемых растворов для взрослых составляет 1-1,5 л, а для детей, в среднем, 10% от массы тела.
|
| Мочегонные препараты | Мочегонные препараты назначаются при наличии отека, который часто бывает на фоне распространенных форм листериоза, а также при менингитах и менингоэнцефалитах. |
|
| Гормональная терапия | Для гормональной терапии при листериозе применяют глюкокортикостероиды. К ним прибегают при тяжелом течении заболевания (нервной форме листериоза, развитии сепсиса). Эффект от гормональной терапии:
|
Применяют курс преднизолона в малых дозах по индивидуальным схемам с постепенным снижением дозы препаратов и кратности приема. При беременности гормональная терапия противопоказана. |
| Препараты, улучшающие мозговое кровообращение | При менингитах и менингоэнцефалитах нарушено мозговое кровообращение, что связано с наличием отека мозга. Улучшение мозгового кровообращения необходимо для снижения риска развития остаточных изменений со стороны нервной системы. | Актовегин, церебролизин, пирацетам, цераксон и другие ноотропные препараты. |
| Плазмаферез | Плазмаферез назначается при бактериемии, развитии сепсиса. Метод основан на фильтрации плазмы крови через мембраны специального аппарата. При этом плазма очищается от токсинов и бактерий и возвращается обратно в кровеносное русло. | Плазмаферез проводится минимум 3 раза. Сеанс плазмафереза длится около 60 минут. |
Помимо антибактериальной, дезинтоксикационной и патогенетической терапии необходимо проводить симптоматическое лечение и лечение сопутствующих патологий (коррекция иммунитета при иммунодефицитах, назначение антивирусной терапии при ВИЧ, коррекция глюкозы крови при сахарном диабете и так далее).
При нарушении работы жизненно важных органов проводят интенсивные и реанимационные мероприятия.
Профилактика листериоза
- Санитарно-эпидемические мероприятия против листериоза:
- надзор за заболеванием листериозом животных,
- контроль над состоянием кормов для животных,
- контроль над зараженным мясом, молоком и другими продуктами питания,
- борьба с грызунами (дератизация) на животноводческих хозяйствах и продуктовых складах,
- надзор за заболеваемостью листериозом среди людей,
- своевременное выявление, диагностика и лечение лиц больных листериозом, их изоляция в инфекционные отделения,
- контроль за инфекциями на мясо- и молокоперерабатывающих производствах, консервных заводах и так далее,
- проведение дезинфекции, дератизации и дезинсекции (уничтожение насекомых) и противоэпидемических мероприятий в хозяйствах, неблагополучных по листериозу,
- контроль над возможным заражением листериями питьевой воды,
- уничтожение трупов животных, умерших от листериоза,
- обеспечение индивидуальными средствами защиты людей профессиональных групп риска по листериозу, их регулярное бактериологическое обследование,
- другие мероприятия.
- Индивидуальные меры защиты от листериоза:
- вакцины против листериоза на данный момент нет,
- употребление в пищу только термически обработанных продуктов, особенно мяса, рыбы, молока,
- тщательное мытье овощей, фруктов и ягод,
- нежелательно употребление полуфабрикатов,
- питье только проверенной и очищенной воды,
- гигиена рук,
- мытье и обработка посуды, разделочных досок, ножей, которые используются для разделывания сырого мяса,
- сортировка сырых и приготовленных продуктов питания во время их хранения,
- регулярное мытье полок холодильника,
- ограничение контакта с животными беременных женщин,
- отказ от употребления брынзы, и других сыров, не проходящих достаточную термическую обработку во время беременности,
- ограничение контакта детей с голубями, дворовыми животными,
- использование индивидуальных средств защиты лицами, которые контактируют с животными, продуктами питания, шерстью, больными листериозом людьми и другие группы риска,
- профессиональная медицинская обработка укусов животных и тому подобное.
- Общие меры профилактики листериоза:
- правильное сбалансированное питание,
- употребление только качественной пищи и воды,
- здоровый образ жизни,
- регулярные медицинские осмотры,
- профилактика ВИЧ, сахарного диабета и других заболеваний.
Важно помнить, что листериозом в большинстве случаев болеют люди со сниженным иммунитетом.
Будьте здоровы!







